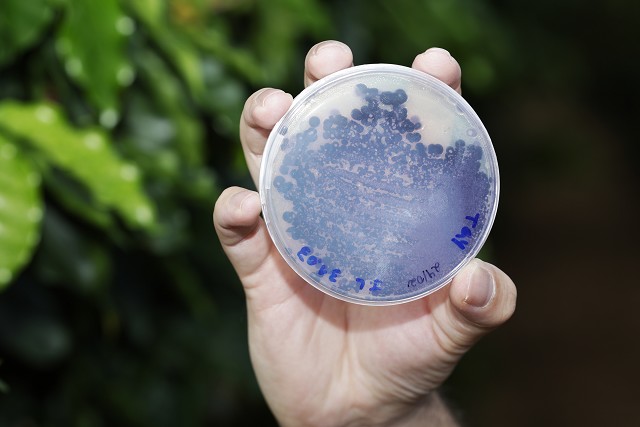
Matéria especial - Visita aos vencedores do Prêmio Assembleia de Incentivo à Inovação - Crise Climática - Empresa Aiper - Fazenda Paraíso

Balanço das atividades de 2025
Eventos consolidam participação social no parlamento
No ano em que a instituição completou 190 anos, fóruns e ações para públicos específicos, como pessoas com deficiência, marcaram presença.
24/12/2025 - 08:56